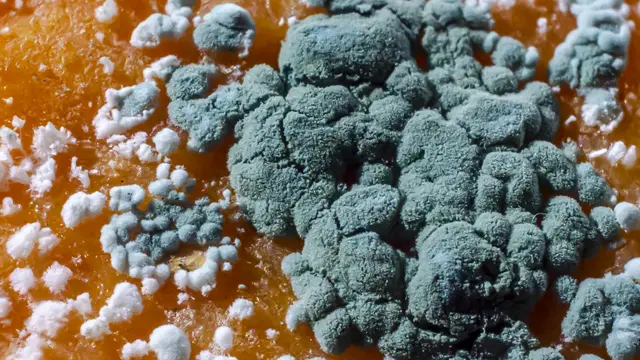
Moho de penicillium en una fruta de naranja

Quién fue Clodomiro Picado Twight y por qué algunos lo consideran el "verdadero" descubridor de la penicilina

Fuente de la imagen, Getty Images
- Autor, Veronica Smink
- Título del autor, BBC News Mundo
- Tiempo de lectura: 6 min
Cuenta la historia que el médico británico Alexander Fleming descubrió la penicilina por casualidad en 1928 cuando trabajaba con cultivos de bacteria y, al irse de vacaciones, sus muestras se cubrieron de un hongo de la cepa Penicillium notatum, que destruyeron las bacterias.
Fleming publicaría sus hallazgos un año más tarde, y en 1945 recibiría el Premio Nobel de Medicina por haber contribuido al desarrollo del primer antibiótico de uso extendido, que salvaría la vida de millones de personas.
Sin embargo, en América Central existe otra historia sobre los orígenes de la penicilina.
Según este relato, un año antes de que Fleming tomara las vacaciones que cambiarían el trascurso de su vida -y de la medicina-, un científico latinoamericano ya había escrito sobre las propiedades antibacteriales del hongo Penicillium.
Además, su hallazgo no había sido fortuito, sino el resultado de más de una década de investigaciones.
Ese hombre se llamaba Clodomiro Picado Twight y fue uno de los científicos más prestigiosos de Costa Rica.
Una vida dedicada a la ciencia
"Clorito" Picado, como lo conocen los costarricenses, provenía de una familia con raíces españolas, del lado paterno, y británicas del lado materno.
Desde joven empezó a hacer aportes científicos: apenas graduado del secundario empezó a enseñar Ciencias Naturales en un colegio y se cree que fue con este fin que escribió sus primeros artículos describiendo las características de la fauna costarricense.

Fuente de la imagen, Instituto Clodomiro Picado
Por sus altas calificaciones el Congreso de Costa Rica le otorgó una beca para que continúe sus estudios superiores en Francia.
Se graduó como zoólogo y botánico en la Universidad de La Sorbona, donde también obtuvo un doctorado en Ciencias Naturales.
Luego se capacitó en el prestigioso Instituto Pasteur de París y en el Instituto de Medicina Colonial.
En ambas instituciones se formó en Microbiología, Inmunología y Química Clínica, por lo que se hizo experto en un amplio espectro de disciplinas científicas.
A su regreso a Costa Rica, en 1914, asumió la dirección del Laboratorio de Análisis Clínicos del Hospital San Juan de Dios, un centro médico estatal en la capital, San José, donde desarrollaría su extensa y prolífica carrera.
Picado introdujo una gran cantidad de análisis de laboratorio como método para diagnosticar enfermedades.
Y trabajando en el hospital, pudo observar y estudiar a través de experimentos una gran cantidad de enfermedades y trastornos.
Aportes
Su variado trabajo experimental le permitió publicar más de 100 investigaciones y libros, tanto en su país como en Francia, sobre diversos aspectos de las ciencias, uno de los mayores legados científicos de América Latina.

Fuente de la imagen, Instituto Clodomiro Picado
Sus eclécticos trabajos incluyen análisis de enfermedades infecciosas, la calidad del agua potable, la fisiopatología de las tiroides y el envejecimiento.
Pero uno de sus mayores aportes fue en el área del ofidismo, como se denomina al envenenamiento causado por las mordeduras de serpientes.
Es que, a además de ser un dedicado científico, Picado era un intelectual comprometido con solucionar los problemas de su país y ayudar a sus compatriotas.
Y uno de los grandes problemas que identificó fue la cantidad de trabajadores agrícolas que eran víctimas de mordeduras de serpientes.
En esa época era común que los dueños de las haciendas echaran a los trabajadores que sufrían este tipo de envenenamiento, para el que no existía cura en Costa Rica.
Picado se enfocó no solo en curar a los heridos, importando sueros antiofídicos del Instituto Butantan, de Brasil, para crear el primer "banco" de sueros del país en su hospital.
También estudió a las serpientes y sus venenos, para desarrollar sueros de producción nacional.
Y en el plano social y político, fomentó la elaboración y aprobación de una "Ley de defensa contra el ofidismo", legislación pionera en América, que obligaba a los hacendados a tener sueros y tratar a sus trabajadores afectados.
¿Qué tiene todo esto que ver con la penicilina?, se estarán preguntando.

Fuente de la imagen, Getty Images
¡Eureka!
Pues, en 1999 dos médicos del Hospital San Juan de Dios que se dedicaron a investigar los muchos manuscritos que dejó Picado, guardados en los archivos del hospital desde su muerte en 1944, anunciaron que entre esos papeles hallaron evidencias de que "Clorito" había descubierto las propiedades de la penicilina años antes que Fleming.
No solo eso, afirmaron que, a diferencia del británico, quien apenas hizo mención al potencial terapéutico de su hallazgo cuando lo publicó en 1929, Picado utilizó levaduras de hongos para tratar a pacientes con enfermedades infecciosas, logrando curarlos.
Incluso señalaron que los resultados de su exitosa terapia fueron publicados por la prestigiosa Sociedad de Biología de París en 1927, es decir, dos años antes de que Fleming diera a conocer los efectos antibióticos de la penicilina.
Los médicos María de los Ángeles San Román y Edgar Cabezas Solera querían que se corrigiera la "injusticia científica" de considerar a Fleming como el descubridor de la penicilina.
"No queremos opacar a Fleming, pero sí es necesario que se reconozca el trabajo del doctor Picado", señaló Cabezas al diario local La Nación.
Desde entonces, muchos costarricenses han mantenido que el verdadero descubridor de la penicilina fue Clorito Picado.
¿Fleming o Picado?
Para desentrañar esta incógnita histórica, BBC Mundo consultó a una de las personas que más estudió el trabajo de Picado Twight.
Se llama José María Gutiérrez, y es profesor emérito en el Instituto Clodomiro Picado (ICP), creado por la Facultad de Microbiología de la Universidad de Costa Rica en 1970, para investigar las serpientes y sus venenos.

Fuente de la imagen, José María Gutiérrez
Gutiérrez, quien en 2019 incluyó un ensayo sobre Picado en su libro "Reflexiones desde la Academia", le explicó a BBC Mundo que el tema del descubrimiento de la penicilina es "un tanto delicado" y requiere una explicación detallada.
Si bien es cierto que el famoso médico costarricense utilizó hongos para tratar enfermedades infecciosas, logrando curar a pacientes con diversas infecciones como fiebres tifoideas, paratifoideas y neumonías, no es correcto afirmar que descubrió la penicilina, dice Gutiérrez.
El motivo es que lo que utilizó Picado para tratar a estos pacientes fue una sustancia extraída de hongos del género Saccharomyces, no el Penicillium, del que viene la penicilina.
Si bien el Saccharomyces tuvo efectos curativos, Picado no pudo develar por qué eran efectivos.
"Él plantea que esas preparaciones generaban una respuesta inmune que protegía contra otros microorganismos también, por eso la llamó 'vacuna terapéutica'", afirma Gutiérrez.
Al día de hoy se desconoce cuál es el mecanismo de protección de la "vacuna terapia" con hongos Saccharomyces, pero no hay evidencia de que tengan un efecto antibiótico, explica el experto.
Aunque su estudio con estas levaduras fue importante, Picado tampoco fue un pionero en esta materia.
"Ya en ese tiempo se manejaba el concepto de que los hongos tenían un efecto sobre bacterias, y diversos investigadores habían hecho observaciones en este sentido, así que me parece que el trabajo de Picado, aunque fue muy valioso, no fue el primero en demostrar efectos de hongos sobre bacterias", dice Gutiérrez.
Fuente de la imagen, Getty Images
Picado también estudió el hongo Penicillium sp., aclara el científico del ICP. Pero solo investigó su efecto sobre plantas.
"En ningún momento Picado describe en este trabajo que estos extractos sean utilizados para estudiar el efecto sobre bacterias que causen enfermedades en el ser humano. Las observaciones se restringieron al efecto de los hongos sobre plantas", detalla.
Legado
No haber sido quien descubrió la penicilina, no empaña, sin embargo, el enorme legado que dejó este hombre, que fue homenajeado a lo largo de su vida no solo por instituciones científicas de Costa Rica y Francia sino también de varios países de América Latina.
"La obra de Clodomiro Picado constituye un punto de referencia fundamental en el desarrollo de la ciencia en Costa Rica y la región", escribió Gutiérrez en una biografía dedicada al científico.
Según el experto, Picado tuvo un papel central en el desarrollo inicial de varias ramas de la ciencia en Costa Rica, entre ellas la Inmunología, la Zoología, la Botánica, la Ecología, la Microbiología Médica e Industrial, la Fisiopatología y la Agronomía.
"El aporte principal de Picado fue haber creado, en condiciones muy difíciles, una tradición científica que ha perdurado hasta hoy en nuestro país", resalta Gutiérrez a BBC Mundo.
Por todo esto, Picado fue declarado "Benemérito de la Patria" por el Congreso costarricense en 1943, un año antes de morir.

Fuente de la imagen, Getty Images
Incluso mucho tiempo después de su muerte, siguió recogiendo tributos. En 1998 el Banco Central de Costa Rica emitió un billete de 2000 colones con su efigie.
Un reconocimiento más que merecido para una de las máximas luminarias científicas de su época.

Ahora puedes recibir notificaciones de BBC Mundo. Descarga la nueva versión de nuestra app y actívalas para no perderte nuestro mejor contenido.
Este artículo contiene contenido proporcionado por Google YouTube. Solicitamos tu permiso antes de que algo se cargue, ya que ese sitio puede estar usando cookies y otras tecnologías. Es posible que quieras leer política de cookies y política de privacidad de Google YouTube antes de aceptar. Para ver este contenido, selecciona 'aceptar y continuar'.
Fin del contenido de YouTube, 1
Este artículo contiene contenido proporcionado por Google YouTube. Solicitamos tu permiso antes de que algo se cargue, ya que ese sitio puede estar usando cookies y otras tecnologías. Es posible que quieras leer política de cookies y política de privacidad de Google YouTube antes de aceptar. Para ver este contenido, selecciona 'aceptar y continuar'.
Fin del contenido de YouTube, 2
Este artículo contiene contenido proporcionado por Google YouTube. Solicitamos tu permiso antes de que algo se cargue, ya que ese sitio puede estar usando cookies y otras tecnologías. Es posible que quieras leer política de cookies y política de privacidad de Google YouTube antes de aceptar. Para ver este contenido, selecciona 'aceptar y continuar'.
Fin del contenido de YouTube, 3











